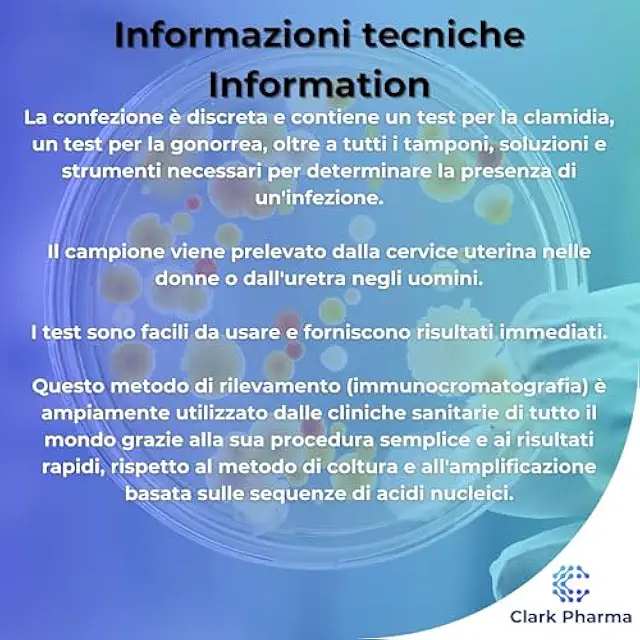
Thumbnail

Kit Test Clamidia e Gonorrea | Test Rapido MST per Uomini e Donne
€9.99

Kit Test Clamidia e Gonorrea | Test Rapido MST
Fornisce risultati rapidi in pochi minuti con alta precisione e affidabilità. Facile da usare tramite tampone, adatto a uomini e donne.
Supporta la diagnosi precoce e il trattamento delle malattie sessualmente trasmissibili.
Ideale per l'uso in strutture mediche o sotto supervisione qualificata.




